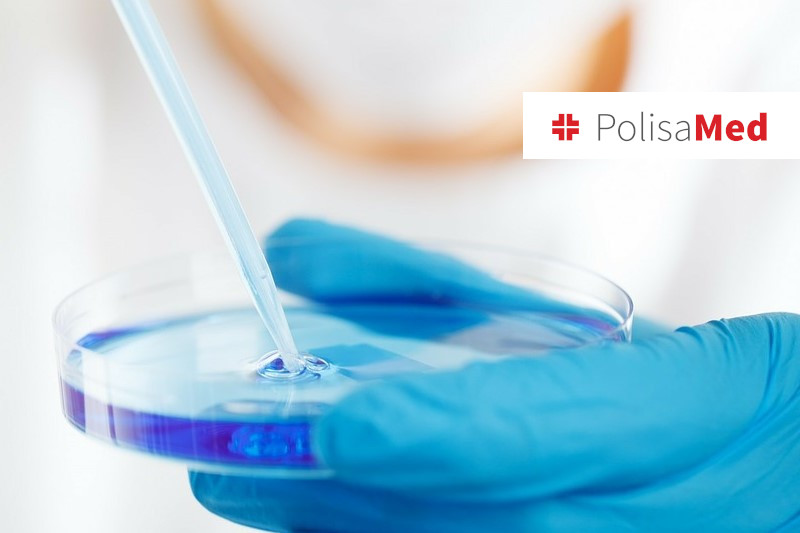

Te pliki cookie gromadzą informacje o tym, w jaki sposób odwiedzający korzystają ze strony, na przykład poprzez analityczne pliki cookie. Nie umożliwiają one bezpośredniej identyfikacji konkretnego użytkownika.
_gid
Nazwa domeny: polisamed.pl
Czas wygaśnięcia: 1 dzień
Dostawca: Google spółka z ograniczoną odpowiedzialnością
Google Analytics ustawia ten plik cookie w celu przechowywania informacji o tym, jak odwiedzający korzystają ze strony internetowej, jednocześnie tworząc raport analityczny na temat wydajności witryny. Niektóre z zebranych danych obejmują liczbę odwiedzających, ich źródło i strony, które odwiedzają anonimowo.
_gat
Nazwa domeny: polisamed.pl
Czas wygaśnięcia: 1 minuta
Dostawca: Google spółka z ograniczoną odpowiedzialnością
Google Universal Analytics ustawia ten plik cookie, aby ograniczyć liczbę żądań, a tym samym ograniczyć gromadzenie danych w witrynach o dużym natężeniu ruchu.
_ga
Nazwa domeny: polisamed.pl
Czas wygaśnięcia: 2 lata
Dostawca: Google spółka z ograniczoną odpowiedzialnością
Rejestruje unikalny identyfikator odwiedzającego witrynę w celu śledzenia sposobu, w jaki odwiedzający korzysta z witryny. Dane służą do celów statystycznych. Przekazywanie danych do krajów trzecich: USA. Google spółka z ograniczoną odpowiedzialnością posiada certyfikat zgodności z Ramami Ochrony Danych, co wskazuje, że Twoje prawa jako osoby, której dane dotyczą, mogą być zagwarantowane.
_ga_**********
Nazwa domeny: polisamed.pl
Czas wygaśnięcia: 2 lata
Dostawca: Google spółka z ograniczoną odpowiedzialnością
Ten plik cookie przechowuje unikalny identyfikator osoby odwiedzającej witrynę i śledzi sposób, w jaki odwiedzający korzysta z witryny. Dane służą do celów statystycznych. Transfer danych. do krajów trzecich: USA. Google spółka z ograniczoną odpowiedzialnością posiada certyfikat zgodności z Ramami Ochrony Danych, co wskazuje, że Twoje prawa jako osoby, której dane dotyczą, mogą być zagwarantowane.
__cf_bm
Nazwa domeny: polisamed.pl
Czas wygaśnięcia: 1 godzina
Dostawca: Vimeo
Ten plik cookie wykorzystywany jest do zarzadzania botami Cloudlare
_cfuvid
Nazwa domeny: polisamed.pl
Czas wygaśnięcia: sesja
Dostawca: Vimeo
vuid
Nazwa domeny: polisamed.pl
Czas wygaśnięcia: 1 rok 1 miesiąc
Dostawca: Vimeo
Vimeo instaluje ten plik cookie w celu gromadzenia informacji o śledzeniu poprzez ustawienie unikalnego identyfikatora w celu osadzania filmów na stronie internetowej.
aka_debug
Nazwa domeny: polisamed.pl
Czas wygaśnięcia: sesja
Dostawca: Vimeo
Vimeo ustawia ten plik cookie, który jest niezbędny, aby witryna mogła odtwarzać funkcje wideo.
__cf_bm
Nazwa domeny: polisamed.pl
Okres przechowywania: 30 minut
Dostawca: Vimeo
Ten plik cookie służy do odróżniania ludzi od botów.